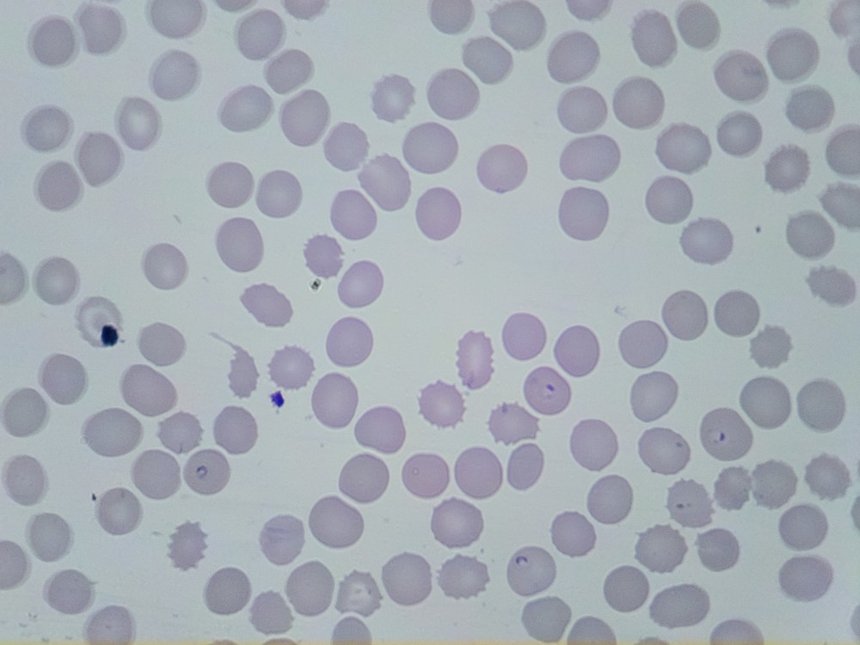
Micrograph of a thin blood smear

Malaria microscopy research
Research into automated digital microscopy for malaria blood smear imaging, supporting training, quality assurance, and data-driven studies in low-resource settings.
Read morePathology imaging research and education
Exploration of automated slide imaging for digital pathology workflows, training, and research, particularly in low-resource and global health contexts.
Read moreUrine microscopy
Exploratory research into the use of OpenFlexure for portable urine microscopy, focusing on imaging workflows for education, training, and infection-related research contexts.
In preparation